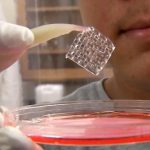

Informazione ed editoria, i quotidiani online inquinano meno

Il quotidiano online e’ amico dell’ambiente e inquina il 90% in meno del quotidiano di carta che per essere prodotto ha bisogno di carta, inchiostro e stampa
I quotidiani online sono amici dell’ambiente. Facilitano la lettura, sono veloci e sono amici dell’ambiente. Inquinano infatti il 90% in meno dei loro cugini, i giornali di carta, che durante la loro produzione emettono gas serra. A dirlo è una ricerca dell’istituto statunitense Rand.
I quotidiani di carta stampata richiedono carta, inchiostro e stampa. Gli analisti hanno calcolato, per un abbonamento annuale singolo a un giornale, un totale di 94,7 chilogrammi di gas serra. Il quotidiano online, invece, è usufruibile dal computer, del telefono, dal tablet o dall’e-reader. Anche la produzione di questi strumenti inquina, ma molto meno. La produzione e la manutenzione di un tablet, per esempio, richiede 35 chilogrammi di gas serra l’anno, mentre per l’e-reader ne sono necessari solo 24,7 chilogrammi di gas serra.
Quindi i giornali online inquinano meno. ‘In queste condizioni il risparmio sarebbe del 63% con il tablet e del 74% con l’e-reader – scrivono gli autori della ricerca – se però si fa l’assunzione più realistica che le emissioni associate con questi dispositivi sono in realtà da ‘spalmare’ non solo sulla lettura del giornale ma anche sulle altre funzioni il risparmio arriva rispettivamente all’84 e all’89%’.
(GC/VG)
Altri articoli consigliati per te:
carta stampata inquina, giornali online, inquinamento giornali, quotidiano online, stampa

I commenti sono chiusi.